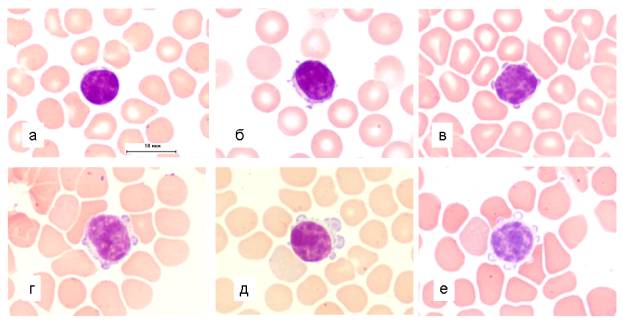

УДК 591.111.1:599.742.1:591.133.16
Биологические
науки/8. Физиология человека и животных
1К.б.н. Баишникова И.В., 1к.б.н. Узенбаева Л.Б., 1к.б.н. Кижина А.Г., 1к.б.н. Ильина Т.Н., 1,2д.б.н. ИлюхаВ.А., 1д.с.-х.н. Тютюнник Н.Н.
1Федеральное
государственное бюджетное учреждение науки Институт биологии Карельского научного
центра Российской академии наук, Россия
2Петрозаводский государственный университет, Россия
Влияние различных доз витаминов А и Е на морфометрические параметры лимфоцитов
периферической крови песцов
Применение современных методов –
компъютерной морфометрии, проточной цитометрии, сканирующей электронной
микроскопии расширило возможности морфологических исследований в гематологии.
Важную роль в регуляции физиологических процессов, в том числе и функционировании
иммунной системы животных, играют витамины А и Е. Целью настоящей работы было
изучение влияния высоких доз витаминов А и Е на морфометрические параметры и особенности
поверхностной архитектоники лимфоцитов периферической крови у вуалевых песцов.
Исследования выполнены с
использованием научного оборудования Центра коллективного пользования ИБ КарНЦ
РАН. Шестимесячным самкам песцов (зверохозяйство
Карелии) в рацион вводили витамин А (ретинола ацетат) в дозе 5000 и 10000 ИЕ и витамин
Е (dl-α-токоферилацетат, Cuxavit E 50,
Германия) в дозе 50 и 100 мг. Контрольные животные получали принятый в
зверохозяйстве рацион. Исследование морфологических особенностей лимфоцитов
проводили на мазках, окрашенных по Паппенгейму на световом микроскопе Axioscop 40 (Carl Zeiss) с компьютерной системой анализа изображений
“Видеотест”. Морфометрические параметры – площадь, процент ядра, фактор формы
круга и фактор формы эллипса определены у 1454 относительно гладких форм
лимфоцитов и у 96 – с выростами и сфероидными образованиями. Кроме
морфологического анализа методом высокоэффективной жидкостной хроматографии в
сыворотке крови определяли концентрацию ретинола и α-токоферола. Полученные
данные обрабатывались с использованием пакетов программ MS Exel и Statgraphics общепринятыми
методами вариационной статистики. Оценку достоверности различий показателей
проводили с применением критериев Вилкоксона-Манна-Уитни и Стьюдента. Работа
выполнена с соблюдением международных принципов Хельсинкской декларации о
гуманном отношении к животным.
В результате исследования установлено, что
в световом микроскопе лимфоциты крови песцов в основном представлены
относительно гладкими формами (рис. 1, а), реже – с цитоплазматическими
выпячиваниями (рис. 1, в–е) и, в единичных случаях – с очень трудно различимыми
нитевидными структурами (рис. 1, б). Морфометрический анализ показал, что цитоплазматические
выросты, за некоторым исключением, приводят к увеличению размера лимфоцитов,
что, возможно, отражает наличие запаса клеточного объема и возможности его
регуляции [4, 5].
Рис. 1. Периферическая-95 кровь вуалевого
песца.
Лимфоциты с относительно гладкой поверхностью (а), с тонкими нитевидными структурами (б), с выростами и со сфероидными образованиями (в-е). Окраска по Паппенгейму. Масляная иммерсия, об. 100, ок. 10.
Известно, что действие витаминов зависит
от ряда факторов, таких как состояние организма, наличие патологии, возраст,
доза и продолжительность введения [9]. Добавка в рацион песцов высоких доз
витаминов А и Е приводит к изменению параметров лимфоцитов, но не влияет на их
относительное содержание в периферической крови. Отсутствие эффекта на общее
количество лимфоцитов, возможно, связано преимущественно с регуляцией витаминами
продукции и функций отдельных типов лейкоцитов. У животных, получавших
витамины, параметры лимфоцитов (клетки и ядра) в большинстве случаев
существенно снижены по сравнению с контролем, что может быть обусловлено
увеличением содержания в крови самых мелких и, наоборот, уменьшением количества
больших лимфоцитов (рис. 2). Смещение кривых распределения лимфоцитов по
площади у животных опытных групп отражает, по-видимому, изменение
внутрипопуляционного соотношения лимфоцитов в крови. В некоторых работах
отмечено стимулирующее влияние бета-каротина, являющегося предшественником
витамина А, на рост тимуса и количество малых лимфоцитов [7]. Уменьшение
площади и нарушение структуры мембран эритроцитов выявлено при
экспериментальном гипервитаминозе А у самцов крыс линии Вистар [3].

Рис. 2. Гистограмма распределения лимфоцитов по площади у
вуалевых песцов при различных дозах витаминов А (А) и Е (Б).
По оси абсцисс – площадь (мкм2), по оси ординат – частота встречаемости лимфоцитов (%).
В крови песцов в содержании лимфоцитов со
сфероидными образованиями достоверных различий между исследованными группами не
выявлено. Однако, у животных, находящихся на рационах с добавкой витамина А,
частота встречаемости их больше и предел колебаний составляет от 0 % до 12.5 %.
Возможно, это связано с повышением уровня ретинола в сыворотке крови. У
животных из группы с витамином Е аналогичное изменение морфологии лимфоцитов
наблюдается, так же, как и у контрольных, в единичных случаях, а их количество
колеблется от 0% до 1.5%.
Исходя из данных литературы, следует, что
способность клетки сохранять определенную форму зависит от состояния и
взаимодействия мембраны и цитоскелета, изменения которых сопровождаются
метаболическими и структурно-функциональными перестройками [1, 2]. Установлено,
что формирование цитоплазматических выростов, так называемый блеббинг, является
обратимым процессом, сопровождающим апоптоз или некроз [2]. В исследуемых нами
образцах крови песцов фигур апоптоза и признаков автомизации клеточных
фрагментов, как правило, не наблюдалось.
Учитывая результаты наших исследований и
имеющиеся данные литературы, можно предположить, что изменение морфологии
клеточной поверхности у животных, содержавшихся на рационах с высокими дозами
витамина А, может быть связано с действием ретинола на мембраны. Проявлением
мембранотропного действия является увеличение количества лизосомальных энзимов
в сыворотке и в лейкоцитах крови кроликов после инъекций ретинола [8]. В наших
экспериментах влияние витамина А на морфологию поверхности лимфоцитов
обнаружено не у всех исследованных животных, что свидетельствует об
индивидуальной чувствительности. Кроме индивидуальных, по-видимому, имеются и
видовые различия, обусловленные особенностями метаболизма, соотношением про-, антиоксидантных
и ряда других факторов, обеспечивающие адаптацию животных к среде обитания. В
частности, имеются сведения о неодинаковой чувствительности к ретиноидам
нейтрофилов морской свинки и человека [6]. Реакция на добавки витаминов может
определяться экологическими особенностями вида – дикого голубого песца, из
которого была селекционирована вуалевая порода.
Таким образом, в периферической крови
вуалевых песцов большинство лимфоцитов представлено относительно гладкими
формами, и незначительное количество имеет выросты и сфероидные образования.
Большие дозы витаминов А и Е вызывают существенное снижение морфометрических
параметров у лимфоцитов с относительно гладкой поверхностью. Частота
встречаемости лимфоцитов с изменениями микрорельефа у животных, находящихся на
рационах с добавлением витамина А, увеличивается по сравнению с контрольными и
получавшими витамин Е. Различия в морфологи и изменении параметров могут быть
обусловлены влиянием высоких доз витаминов А и Е на структурно-функциональное
состояние мембран и зависеть от вида животных.
Работа выполнена при финансовой поддержке гранта
Президента НШ-1642.2012.4 и ФЦП ГК № 02.740.11.0700.
ЛИТЕРАТУРА
1. Егорова А.Б., Успенская Ю.А., Михуткина С.В.,
Ставицкая Е.Ю. Повреждение цитоскелета и клеточных мембран при апоптозе. Успехи
соврем. биол., 2001, т. 121, № 5, с. 502–510.
2. Инжутова А.И., Салмина А.Б., Петрова М.М.,
Михуткина С. В., Народова В.В., Домрачев Д.В. Регистрация блеббинга
плазматической мембраны лимфоцитов периферической крови как экспресс-метод
оценки тяжести состояния больных осложненными формами гипертонической болезни.
Бюл. СО РАМН, 2007, № 1 (123), с. 6–10.
3. Минашкина Т.А. Морфологическая характеристика
эритроцитов при экспериментальном гипервитаминозе А. Морфология, 2011, т. 139,
№ 2, с. 41–44.
4. Скоркина М.Ю., Федорова М.З., Муравьев А.В.
Цитоархитектоника лимфоцитов здоровых доноров в условиях активации и блокады
β-адренорецепторов. Ярославский педагогический вестник, 2011, т. III, № 3, с. 104–109.
5. Редчиц Е.Г., Парфенов А.С. Реологические свойства
лейкоцитов и их участие в микроциркуляции крови. Гематол. и трасфузиол., 1989, т. 34. № 12, с. 40–45.
6. Badwey J.A.,
Robinson J.M., Curnutte J.T., Karnovsky M. J. and Karnovsky M. L. Retinoids
Stimulate the Release of Superoxide by Neutrophils and Change Their Morphology.
J. Cell. Physiol., 1986, v. 127, p. 223–228.
7. Chew B.P. and
Park J.S. Carotenoid Action on the Immune Response. J. Nutr., 2004, v. 134, p.
257S–261S.
8. Schmidt M.,
Kotataj A., Bulla J., Krol T., Witek B. and Banasik A. Activity of Some
Lysosomal Enzymes in Plasma and Leucocytes of Rabbits Exposed to Effect of
Retinol and Hydrocortisone. Horm. metab., 1992, v. 24, p. 21–25.
9. Webb A.L. and
Villamor E. Update : Effects of Antioxidant and Non-Antioxidant Vitamin
Supplementation on Immune Function. Nutrition Reviews. 2007, v. 65, № 5, p.
181–217.